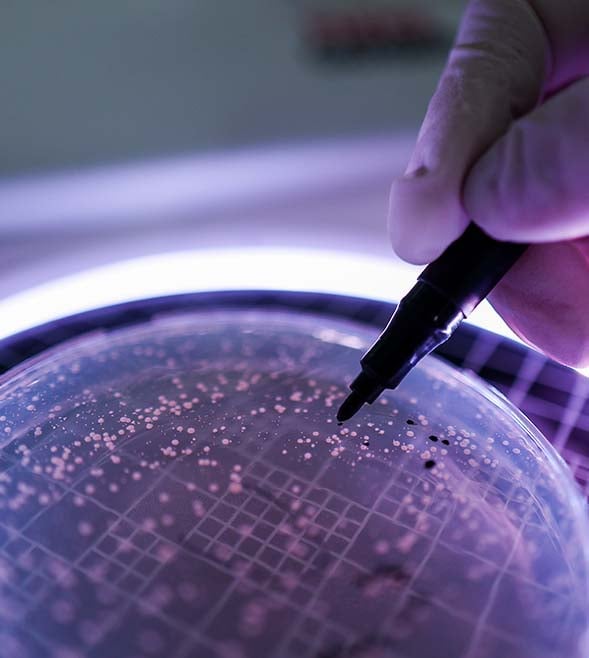
Turning biotech research into global opportunity

Biotechnology is at the forefront of innovation, driving progress in healthcare, agriculture, environmental sustainability and more.
Currently, the industry faces challenges, including regulatory pressures, supply chain disruption, rising production costs and shifting investment landscapes. The push for domestic manufacturing, coupled with global trade uncertainties, is prompting biotech leaders to rethink operations and financial strategies.
Success in this evolving market requires a strategic approach to funding, supply chain resilience, and policy engagement. Proactively addressing these challenges will help position your business for long-term success.
Strengthening supply chain resilience
Supply chain disruptions remain a concern, particularly with changing tariffs, geopolitical shifts, and a stronger emphasis on local manufacturing – particularly in the United States - impacting biotech operations and commercialisation. Those that rely on global suppliers for raw materials, clinical trials, or for export must consider the impact of these changes, which can lead to higher costs, potential shortages, and increased barriers to market entry.
To mitigate these risks, biotechs can consider diversifying their supply chain to reduce dependence on any single source or jurisdiction. This not only helps create a more stable supply of materials, but also makes costs more predictable. Leveraging advanced logistics, predictive analytics, and digital supply chain management tools can further improve inventory management and minimise disruption.
Securing funding in a competitive market
Despite market fluctuations, investor interest in the life science industry remains strong, with venture capital, R&D incentives, government grants, and strategic partnerships providing various funding opportunities. However, securing investment requires a clear business strategy, strong leadership, and robust financial planning.
Biotechs can increase their appeal to investors by demonstrating a well-defined path to commercialisation, showing encouraging results, tangible market potential, and having the support of an experienced management team that can navigate regulatory and financial complexities. Collaborations with pharmaceutical companies or other industry partners can also provide additional financial support, technical expertise, and broaden market access. Additionally, in a measure to support innovative companies in Australia, tax incentives may be available for early-stage investors in qualifying Early Stage Innovation Companies, such as startups in the biotech sector with high growth potential.
Furthermore, biotechs should consider leveraging the Research and Development (R&D) Tax Incentive and government grants throughout their lifecycle. Early-stage companies focusing on foundational research often benefit from the R&D Tax Incentive, similarly mid-stage firm soften continue to rely on the R&D Incentive while also considering targeted government grants. Later-stage companies looking for commercialisation support can tap into incentive programs designed to accelerate market entry and expansion, including the current Industry Growth Program.
Strategic planning, innovation, and policy engagement
Long-term success in biotech hinges on balancing innovation with regulatory compliance and market demands. Emerging technologies such as artificial intelligence-driven drug discovery are reshaping the industry, so it’s important to stay ahead and integrate these advancements into R&D strategies.
Active engagement with policymakers is equally important. Biotech leaders should collaborate with industry associations, contribute to regulatory discussions, and advocate for policies that streamline approval processes and support innovation. Establishing relationships with policymakers and adopting a solution-driven approach can not only help shape a more favourable regulatory environment, but also contributes towards your organisation’s reputation.
Next steps
To remain competitive, biotech firms should focus on strengthening supply chains, securing diverse funding sources, and adopting a strategic approach to innovation and policy advocacy. By taking these proactive steps, they can strengthen their position in the market and drive sustainable growth.
If you need advice on navigating regulatory changes, optimising financial strategies, or securing funding, our experts are here to help. Get in touch to explore how we can help you capital raise, access R&D Incentives and grants or manage the current supply chain landscape.
Learn more about how our Life Sciences services can help you